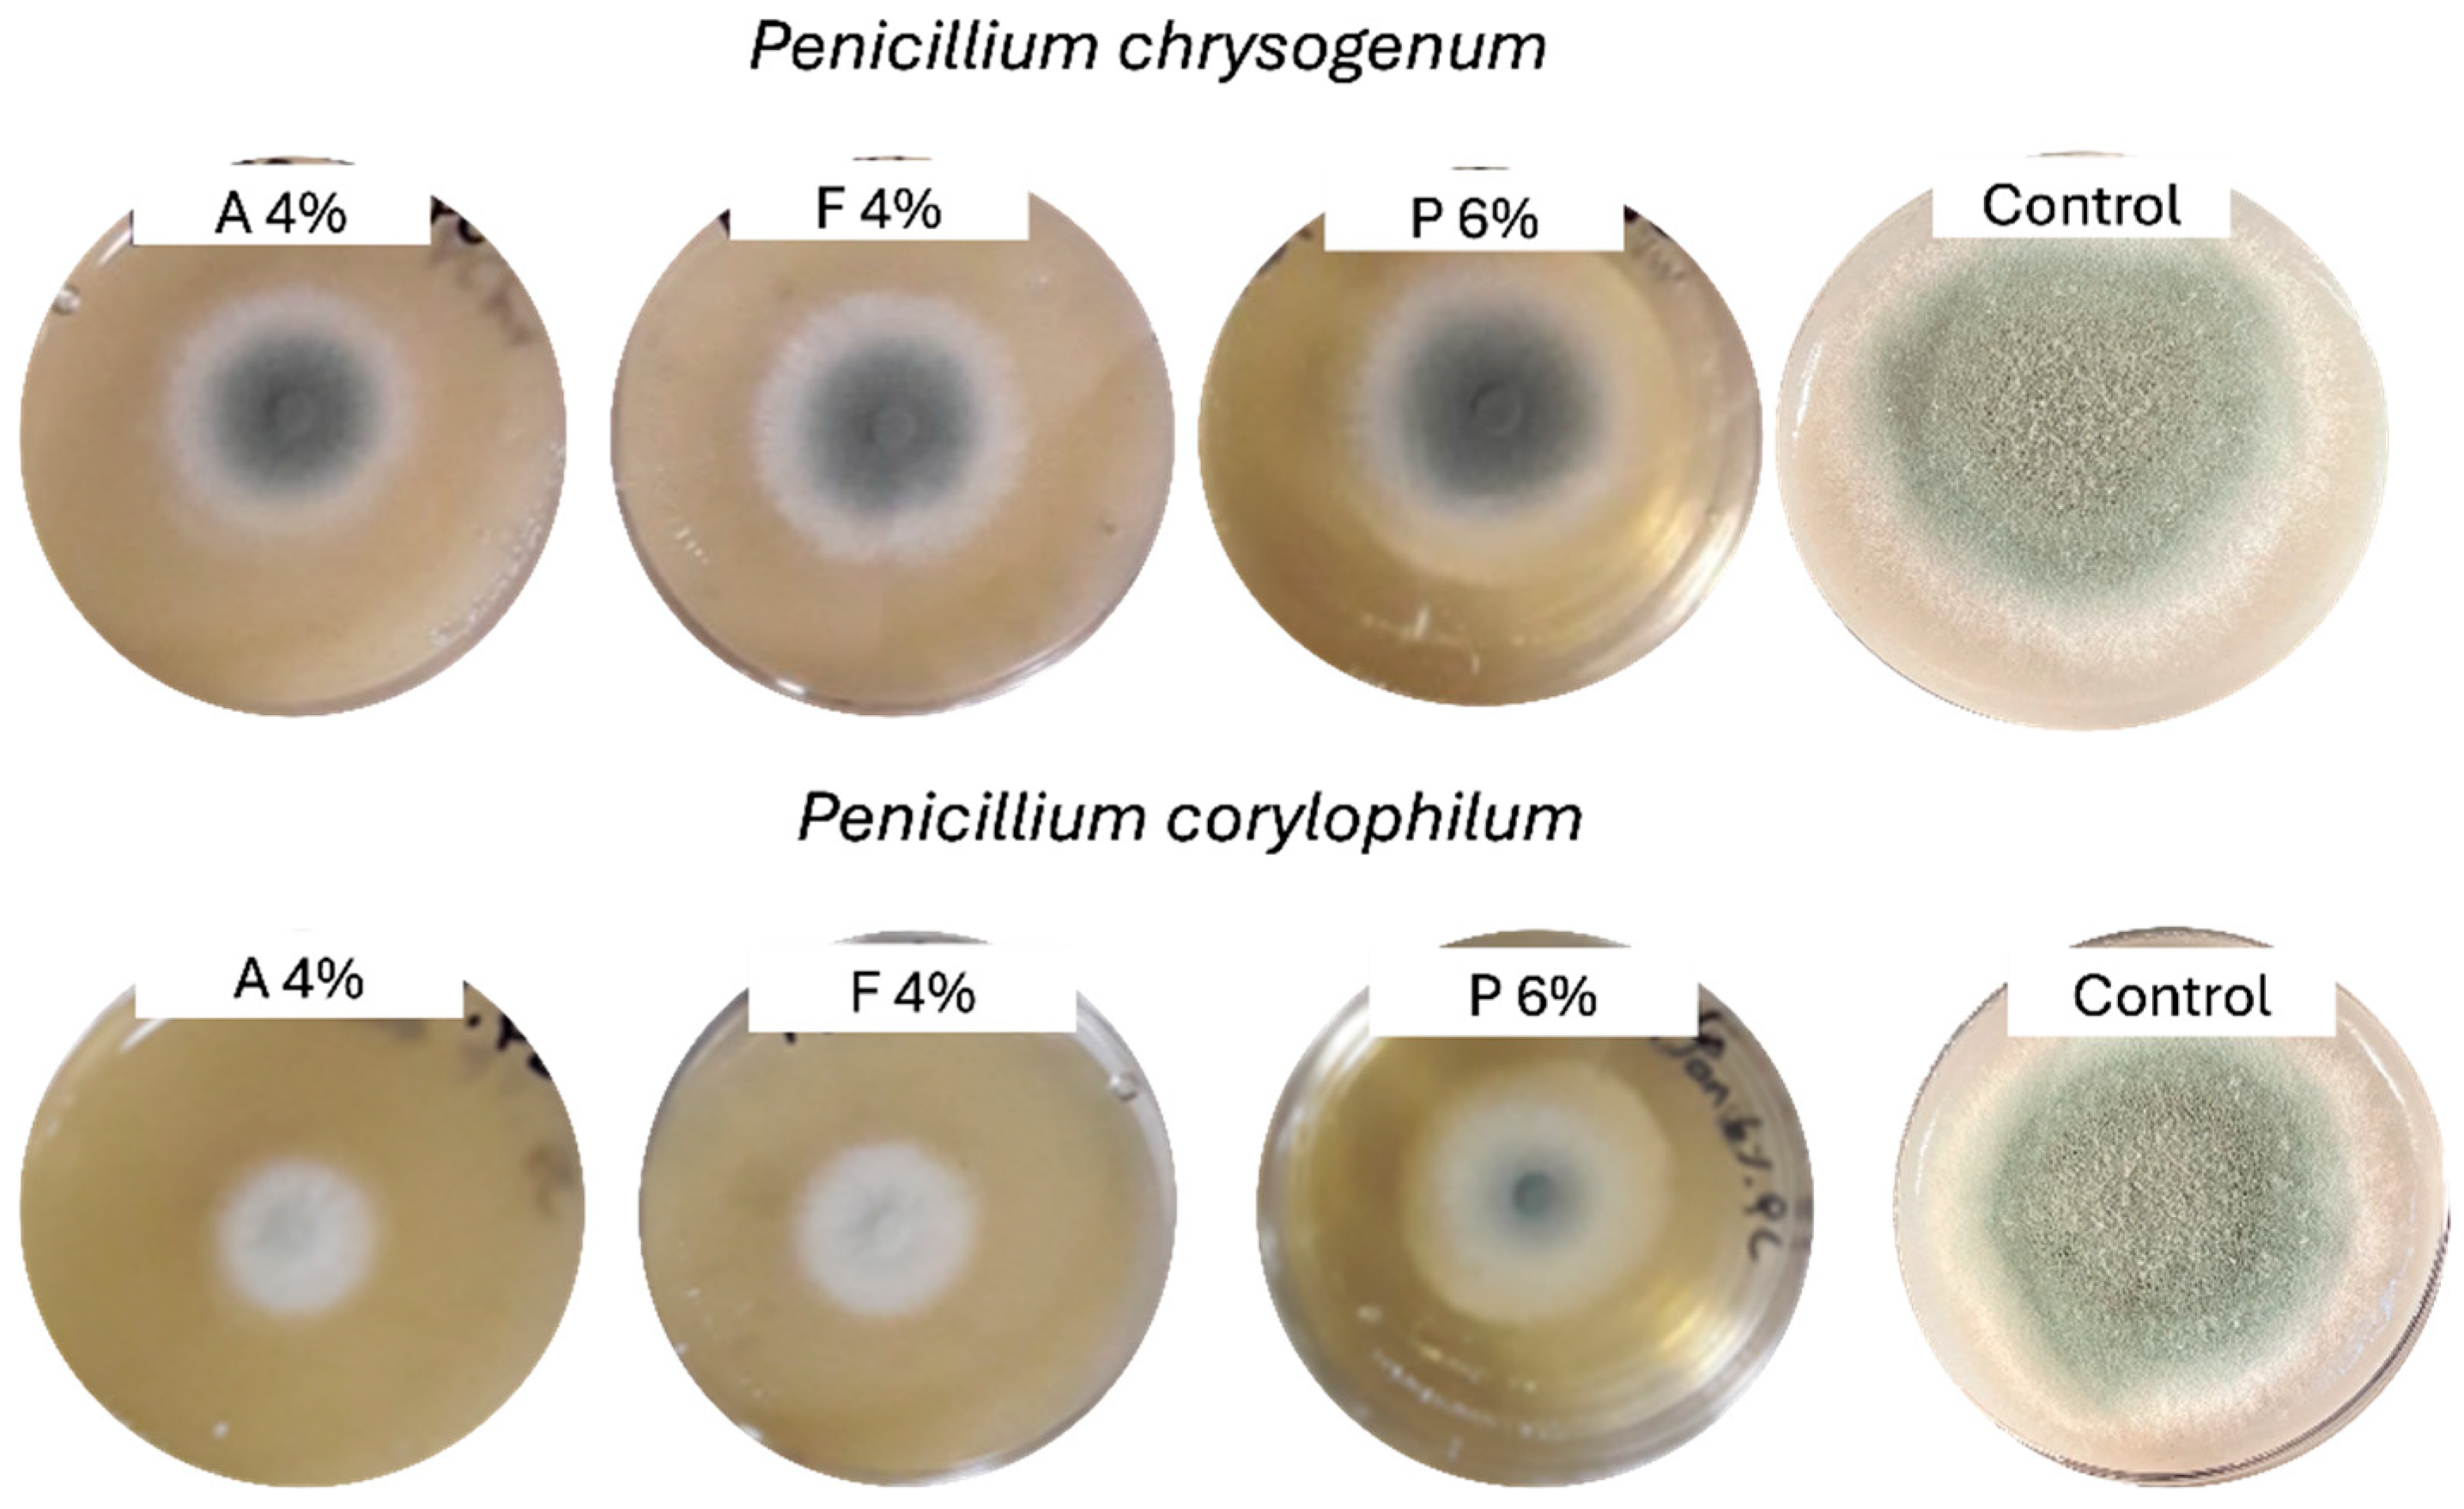
Microbiolres 16 00179 g001 Microbiolres 16 00179 g001

Evaluation of Clean-Label Additives to Inhibit Molds and Extend the Shelf Life of Preservative-Free Bread
Abstract
1. Introduction
2. Materials and Methods
2.1. Materials and Mold Culture Conditions
2.2. Antifungal Effect of Selected Commercial Fermentates In Vitro
2.3. Physicochemical Properties of Selected Commercial Fermentates
2.4. Antimicrobial Effect of Commercial Extracts on Bread
2.5. Modeling the Time to Growth
2.6. Bread Physicochemical Properties
2.7. Statistical Analysis
3. Results and Discussion
3.1. Physicochemical Properties and Antifungal Activity of Selected Fermentates In Vitro
3.2. Antifungal Activity of Fermentates or Extracts on Bread
3.3. Time-to-Growth Model for Fermentates A and F
3.4. Physicochemical Characteristics of Bread Formulated with Commercial Fermentates
4. Conclusions
Supplementary Materials
Author Contributions
Funding
Institutional Review Board Statement
Informed Consent Statement
Data Availability Statement
Acknowledgments
Conflicts of Interest
References
- Gerez, C.L.; Torino, M.I.; Rollán, G.; de Valdez, G.F. Prevention of bread mould spoilage by using lactic acid bacteria with antifungal properties. Food Control 2009, 20, 144–148. [Google Scholar] [CrossRef]
- Saladino, F.; Luz, C.; Manyes, L.; Fernández-Franzón, M.; Meca, G. In vitro antifungal activity of lactic acid bacteria against mycotoxigenic fungi and their application in loaf bread shelf life improvement. Food Control 2016, 67, 273–277. [Google Scholar] [CrossRef]
- Peyer, L.C.; Zannini, E.; Arendt, E.K. Lactic acid bacteria as sensory biomodulators for fermented cereal-based beverages. Trends Food Sci. Technol. 2016, 54, 17–25. [Google Scholar] [CrossRef]
- Ibrahim, S.A.; Ayivi, R.D.; Zimmerman, T.; Siddiqui, S.A.; Altemimi, A.B.; Fidan, H.; Esatbeyoglu, T.; Bakhshayesh, R.V. Lactic acid bacteria as antimicrobial agents: Food safety and microbial food spoilage prevention. Foods 2021, 10, 3131. [Google Scholar] [CrossRef] [PubMed]
- Hernández-Figueroa, R.H.; López-Malo, A.; Mani-López, E. Antimicrobial activity and applications of fermentates from lactic acid bacteria–a review. Sustain. Food Technol. 2024, 2, 292–306. [Google Scholar] [CrossRef]
- Asioli, D.; Aschemann-Witzel, J.; Caputo, V.; Vecchio, R.; Annunziata, A.; Næs, T.; Varela, P. Making sense of the “clean label” trends: A review of consumer food choice behavior and discussion of industry implications. Food Res. Int. 2017, 99, 58–71. [Google Scholar] [CrossRef] [PubMed]
- EFSA BIOHAZ Panel (EFSA Panel on Biological Hazards); Koutsoumanis, K.; Allende, A.; Alvarez-Ordóñez, A.; Bolton, D.; Bover-Cid, S.; Chemaly, M.; Davies, R.; De Cesare, A.; Hilbert, F.; et al. Statement on the Update of the list of QPS-recommended biological agents intentionally added to food or feed as notified to EFSA 12: Suitability of taxonomic units notified to EFSA until March 2020. EFSA J. 2020, 18, 6174. [Google Scholar] [CrossRef]
- Ayiyi, R.D.; Gyawali, R.; Krastanov, A.; Aljaloud, S.O.; Worku, M.; Tahergorabi, R.; da Silva, R.C.; Ibrahim, S.A. Lactic acid bacteria. Food safety and human health applications. Dairy 2020, 1, 202–232. [Google Scholar] [CrossRef]
- Anumudu, C.K.; Miri, T.; Onyeaka, H. Multifunctional applications of lactic acid bacteria: Enhancing safety, quality, and nutritional value in foods and fermentes beverages. Foods 2024, 13, 3714. [Google Scholar] [CrossRef] [PubMed]
- Bangar, S.P.; Sharma, N.; Kumar, M.; Ozogul, F.; Purewal, S.S.; Trif, M. Recent developments in applications of lactic acid bacteria against mycotoxin production and fungal contamination. Food Biosci. 2021, 44, 101444. [Google Scholar] [CrossRef]
- Ponzio, A.; Rebecchi, A.; Zivoli, R.; Morelli, L. Reuterin, phenyllactic acid, and exopolysaccharides as main antifungal molecules produced by lactic acid bacteria: A scoping review. Foods 2024, 13, 752. [Google Scholar] [CrossRef] [PubMed]
- Gálvez, A.; Abriouel, H.; López, R.L.; Omar, N.B. Bacteriocin-based strategies for food biopreservation. Int. J. Food Microbiol. 2007, 120, 51–70. [Google Scholar] [CrossRef] [PubMed]
- Nasrollahzadeh, A.; Mokhtari, S.; Khomeiri, M.; Saris, P.E. Antifungal preservation of food by lactic acid bacteria. Foods 2022, 11, 395. [Google Scholar] [CrossRef] [PubMed]
- Leyva Salas, M.; Mounier, J.; Valence, F.; Coton, M.; Thierry, A.; Coton, E. Antifungal microbial agents for food biopreservation—A review. Microorganisms 2017, 5, 37. [Google Scholar] [CrossRef] [PubMed]
- Mathur, H.; Beresford, T.P.; Cotter, P.D. Health benefits of lactic acid bacteria (LAB) fermentates. Nutrients 2020, 12, 1679. [Google Scholar] [CrossRef] [PubMed]
- De Vuyst, L.; Van Kerrebroeck, S.; Harth, H.; Huys, G.; Daniel, H.M.; Weckx, S. Microbial ecology of sourdough fermentations: Diverse or uniform? Food Microbiol. 2014, 37, 11–29. [Google Scholar] [CrossRef] [PubMed]
- Galle, S. Sourdough: A tool to improve bread structure. In Handbook on Sourdough Biotechnology; Gobbetti, M., Gänzle, M., Eds.; Springer: New York, NY, USA, 2012; pp. 217–228. [Google Scholar] [CrossRef]
- Rizzello, C.G.; Lorusso, A.; Montemurro, M.; Gobbetti, M. Use of sourdough made with quinoa (Chenopodium quinoa) flour and autochthonous selected lactic acid bacteria for enhancing the nutritional, textural and sensory features of white bread. Food Microbiol. 2016, 56, 1–13. [Google Scholar] [CrossRef] [PubMed]
- Kerry Group PLC. Ingredients for Clean-Label Preservation, Fermentate-Based Ingredients. Available online: https://www.kerry.com/products/food-protection-and-preservation/clean-label-preservation (accessed on 2 April 2025).
- AB Mauri. Mild Inhibitors–Nabitor® 2025. Available online: https://abmauri.ae/product/mold-inhibitors-nabitor/ (accessed on 2 April 2025).
- IFF, International Flavors & Fragances Inc. Bakery 2025. Available online: https://www.iff.com/food-beverage/food-ingredients/food-protection/ (accessed on 2 April 2025).
- Dairy Connection Inc, Fermentates. 2025. Available online: https://dairyconnection.com/antimicrobial/fermentates/?mode=1 (accessed on 2 April 2025).
- Puratos. Sapore 2025. Available online: https://www.puratos.com/products/sapore (accessed on 2 April 2025).
- Coda, R.; Cassone, A.; Rizzello, C.G.; Nionelli, L.; Cardinali, G.; Gobbetti, M. Antifungal activity of Wickerhamomyces anomalus and Lactobacillus plantarum during sourdough fermentation: Identification of novel compounds and long-term effect during storage of wheat bread. Appl. Environ. Microbiol. 2011, 77, 3484–3492. [Google Scholar] [CrossRef] [PubMed]
- Rizzello, C.G.; Cassone, A.; Coda, R.; Gobbetti, M. Antifungal activity of sourdough fermented wheat germ used as an ingredient for bread making. Food Chem. 2011, 127, 952–959. [Google Scholar] [CrossRef] [PubMed]
- Ryan, L.A.M.; Zannini, E.; Dal Bello, F.; Pawlowska, A.; Koehler, P.; Arendt, E.K. Lactobacillus amylovorus DSM 19280 as a novel food-grade antifungal agent for bakery products. Int. J. Food Microbiol. 2011, 146, 276–283. [Google Scholar] [CrossRef] [PubMed]
- Black, B.A.; Zannini, E.; Curtis, J.M.; Gänzle, M.G. Antifungal hydroxy fatty acids produced during sourdough fermentation: Microbial and enzymatic pathways, and antifungal activity in bread. Appl. Environ. Microbiol. 2013, 79, 1866–1873. [Google Scholar] [CrossRef] [PubMed]
- Gerez, C.L.; Fornaguera, M.J.; Obregozo, M.D.; Font De Valdez, G.; Torino, M.I. Antifungal starter culture for packed bread: Influence of two storage conditions. Rev. Argent. Microbiol. 2015, 47, 118–124. [Google Scholar] [CrossRef] [PubMed]
- Axel, C.; Brosnan, B.; Zannini, E.; Furey, A.; Coffey, A.; Arendt, E.K. Antifungal sourdough lactic acid bacteria as biopreservation tool in quinoa and rice bread. Int. J. Food Microbiol. 2016, 239, 86–94. [Google Scholar] [CrossRef] [PubMed]
- Mohsen, S.M.; Aly, M.H.; Attia, A.A.; Osman, D.B. Effect of sourdough on shelf life, freshness and sensory characteristics of Egyptian Balady bread. J. Appl. Environ. Microbiol. 2016, 4, 39–45. [Google Scholar]
- Hernández-Figueroa, R.H.; Mani-López, E.; López-Malo, A. Antifungal capacity of poolish-type sourdough supplemented with Lactiplantibacillus plantarum and its aqueous extracts in vitro and bread. Antibiotics 2022, 11, 1813. [Google Scholar] [CrossRef] [PubMed]
- Hernández-Figueroa, R.H.; Mani-López, E.; López-Malo, A. Antifungal activity of wheat-flour sourdough (Type II) from two different Lactobacillus in vitro and bread. Appl. Food Res. 2023, 3, 100319. [Google Scholar] [CrossRef]
- Hernández-Figueroa, R.H.; Mani-López, E.; Ramírez-Corona, N.; López-Malo, A. Optimizing lactic acid bacteria proportions in sourdough to enhance antifungal activity and quality of partially and fully baked bread. Foods 2024, 13, 2318. [Google Scholar] [CrossRef] [PubMed]
- Hussain, S.A.; Garg, F.C.; Pal, D. Effect of different preservative treatments on the shelf-life of sorghum malt based fermented milk beverage. J. Food Sci. Technol. 2014, 51, 1582–1587. [Google Scholar] [CrossRef] [PubMed][Green Version]
- Makhal, S.; Kanawjia, S.K.; Giri, A. Effect of MicroGARD on keeping quality of direct acidified cottage cheese. J. Food Sci. Technol. 2015, 52, 936–943. [Google Scholar] [CrossRef] [PubMed]
- Samapundo, S.; De Baenst, I.; Eeckhout, M.; Devlieghere, F. Inhibitory activity of fermentates towards Zygosaccharomyces bailii and their potential to replace potassium sorbate in dressings. LWT—Food Sci. Technol. 2017, 79, 309–315. [Google Scholar] [CrossRef]
- Samapundo, S.; Devlieghere, F.; Vroman, A.; Eeckhout, M. Antifungal properties of fermentates and their potential to replace sorbate and propionate in pound cake. Int. J. Food Microbiol. 2016, 237, 157–163. [Google Scholar] [CrossRef] [PubMed]
- Samapundo, S.; Devlieghere, F.; Vroman, A.; Eeckhout, M. Antifungal activity of fermentates and their potential to replace propionate in bread. LWT—Food Sci. Technol. 2017, 76, 101–107. [Google Scholar] [CrossRef]
- Association of Official Analytical Chemists (AOAC). Official Methods of Analysis of AOAC International, 19th ed.; The Association of Official Analytical Chemists: Gaithersburg, MD, USA, 2012. [Google Scholar]
- Sneath, P.H.A.; Mair, N.S.; Sharpe, M.E.; Holt, J.G. Bergey’s Manual of Systematic Bacteriology; Williams & Wilkins: New York, NY, USA, 1986; Volume 2. [Google Scholar]
- Mani-López, E.; Arrioja-Bretón, D.; López-Malo, A. The impacts of antimicrobial and antifungal activity of cell-free supernatants from lactic acid bacteria in vitro and foods. Compr. Rev. Food Sci. Food Saf. 2022, 21, 604–641. [Google Scholar] [CrossRef] [PubMed]
- Axel, C.; Zannini, E.; Arendt, E.K. Mold spoilage of bread and its biopreservation: A review of current strategies for bread shelf life extension. Crit. Rev. Food Sci. Nutr. 2017, 57, 3528–3542. [Google Scholar] [CrossRef] [PubMed]
- Arendt, E.K.; Ryan, L.A.M.; Dal Bello, F. Impact of sourdough on the texture of bread. Food Microbiol. 2007, 24, 165–174. [Google Scholar] [CrossRef] [PubMed]
- Corsetti, A.; Gobbetti, M.; Rossi, J.; Damiani, P. Antimould activity of sourdough lactic acid bacteria: Identification of a mixture of organic acids produced by Lactobacillus sanfrancisco CB1. Appl. Microbiol. Biotechnol. 1998, 50, 253–256. [Google Scholar] [CrossRef] [PubMed]
- Rogawansamy, S.; Gaskin, S.; Taylor, M.; Pisaniello, D. An evaluation of antifungal agents for the treatment of fungal contamination of indoor air environments. Int. J. Environ. Res. Public Health 2015, 12, 6319–6332. [Google Scholar] [CrossRef] [PubMed]
- Dantigny, P. Applications of predictive modeling techniques to fungal growth in foods. Curr. Opin. Food Sci. 2021, 38, 86–90. [Google Scholar] [CrossRef]
- Marín, S.; Freire, L.; Femenias, A.; Sant’Ana, A.S. Use of predictive modelling as tool for prevention of fungal spoilage at different points of the food chain. Curr. Opin. Food Sci. 2021, 41, 1–7. [Google Scholar] [CrossRef]
- Dagnas, S.; Membré, J.-M. Predicting and preventing mold spoilage of food products. J. Food Prot. 2013, 76, 538–551. [Google Scholar] [CrossRef] [PubMed]
- Zhang, Y.; Wang, D.; Zhang, Z.; Guan, H.; Zhang, Y.; Xu, D.; Xu, X.; Li, D. Improvement on wheat bread quality by in situ produced dextran—A comprehensive review from the viewpoint of starch and gluten. Compr. Rev. Food Sci. Food Saf. 2024, 23, e13353. [Google Scholar] [CrossRef] [PubMed]
- Guynot, M.E.; Marín, S.; Sanchis, V.; Ramos, A.J. Modified atmosphere packaging for prevention of mold spoilage of bakery products with different pH and water activity levels. J. Food Prot. 2003, 66, 1864–1872. [Google Scholar] [CrossRef] [PubMed]
- Dal Bello, F.; Clarke, C.I.; Ryan, L.A.M.; Ulmer, H.; Schober, T.J.; Ström, K.; Sjögren, J.; van Sinderen, D.; Schnürer, J.; Arendt, E.K. Improvement of the quality and shelf life of wheat bread by fermentation with the antifungal strain Lactobacillus plantarum FST 1.7. J. Cereal Sci. 2007, 45, 309–318. [Google Scholar] [CrossRef]
- Rahimi, D.; Auld, K.; Sadeghi, A.; Kashaninejad, M.; Ebrahimi, M.; Zhang, J.; Gänzle, M.G. Optimising bread preservation: Use of sourdough in combination with other clean label approaches for enhanced mould-free shelf life of bread. Eur. Food Res. Technol. 2025, 251, 1269–1278. [Google Scholar] [CrossRef]
- Lafuente, C.; Nazareth, T.M.; Dopazo, V.; Meca, G.; Luz, C. Enhancing bread quality and extending shelf life using dried sourdough. LWT—Food Sci. Technol. 2024, 203, 116379. [Google Scholar] [CrossRef]
- Lafuente, C.; Calpe, J.; Musto, L.; Nazareth, T.D.; Dopazo, V.; Meca, G.; Luz, C. Preparation of sourdoughs fermented with isolated lactic acid bacteria and characterization of their antifungal properties. Foods 2023, 12, 686. [Google Scholar] [CrossRef] [PubMed]
- Teixeira, L.B.; Campos, J.Z.; Kothe, C.I.; Welke, J.E.; Rodrigues, E.; Frazzon, J.; Thys, R.C.S. Type III sourdough: Evaluation of biopreservative potential in bakery products with enhanced antifungal activity. Food Res. Int. 2024, 189, 114482. [Google Scholar] [CrossRef] [PubMed]

| Fermentate | Tested Concentration (%) | Tests Performed | |
|---|---|---|---|
| 100 | 1.5 | Bread | |
| 200 | 1.5 | Bread | |
| 300 | 1.5 | Bread | |
| 520 | 0.5 | Bread | |
| CS1-50 CO | 1 | Bread | |
| 730 | 1.5 | Bread | |
| 910 | 1 | Bread | |
| P | 1.5 | In Vitro | |
| P | 3 | In Vitro | |
| P | 4 | Bread | |
| P | 6 | In Vitro | |
| T | 4 | Bread | |
| R | 4 | Bread | |
| A | 1 | In Vitro | |
| A | 2 | In Vitro | |
| A | 4 | Bread | |
| A | 6 | Bread | |
| A | 8 | Bread | |
| F | 1 | In Vitro | |
| F | 2 | In Vitro | |
| F | 4 | Bread | In Vitro |
| F | 6 | Bread | |
| F | 12 | Bread | |
| Calcium propionate | 0.3 | Bread | |
| Control | 0 | Bread | In Vitro |
| Fermentate | pH | Titratable Acidity (%) | Lactic Acid (mmol/L) | Acetic Acid (mmol/L) | Manufacturer’s Declared pH (Minimum–Maximum) |
|---|---|---|---|---|---|
| A | 2.61 ± 0.1 | 10.18 ± 0.01 * | 1053.6 ± 5.4 | 1061.3 ± 4.7 | 2.1–2.8 |
| F | 2.73 ± 0.1 | 10.81 ± 0.05 ** | 1002.1 ± 3.9 | 384.7 ± 3.2 | 2.2–3.0 |
| P | 3.77 ± 0.02 | 0.21 ± 0.01 * | 48.2 ± 2.2 | 138.1 ± 4.1 | 3.3–4.0 |
| Fermentate | Concentration (%) | Penicillium corylophilum | Penicillium chrysogenum |
|---|---|---|---|
| A | 1 | 51.90 ± 1.08 c | 32.26 ± 0.48 b |
| A | 2 | 56.78 ± 0.34 b | 33.88 ± 0.37 a |
| A | 4 | 62.60 ± 1.10 a | 34.49 ± 0.23 a |
| F | 1 | 41.33 ± 1.01 b | 25.62 ± 0.47 ab |
| F | 2 | 45.20 ± 0.86 a | 23.30 ± 0.53 b |
| F | 4 | 46.27 ± 0.36 a | 28.48 ± 2.11 a |
| P | 1.5 | 25.22 ± 0.81 c | 25.56 ± 0.30 c |
| P | 3 | 36.74 ± 0.70 b | 30.33 ± 0.42 b |
| P | 6 | 38.81 ± 0.65 a | 37.11 ± 0.36 a |
| Fermentate | Concentration (%) | Time (Days) * |
|---|---|---|
| Control | 0 | 4 |
| 100 | 1.5 | 6 |
| 200 | 1.5 | 8 |
| 300 | 1.5 | 6 |
| 520 | 0.5 | 7 |
| CS1-50 CO | 1 | 7 |
| 730 | 1.5 | 7 |
| 910 | 1 | 13 |
| P | 4 | 5 |
| T | 4 | 6 |
| R | 4 | 5 |
| Calcium propionate | 0.3 | 19 |
| A | 4 | 9 |
| 6 | 18 | |
| 8 | >25 | |
| F | 4 | 7 |
| 6 | 20 | |
| 12 | >25 |
Disclaimer/Publisher’s Note: The statements, opinions and data contained in all publications are solely those of the individual author(s) and contributor(s) and not of MDPI and/or the editor(s). MDPI and/or the editor(s) disclaim responsibility for any injury to people or property resulting from any ideas, methods, instructions or products referred to in the content. |
© 2025 by the authors. Licensee MDPI, Basel, Switzerland. This article is an open access article distributed under the terms and conditions of the Creative Commons Attribution (CC BY) license (https://creativecommons.org/licenses/by/4.0/).
Share and Cite
Hernández-Figueroa, R.H.; López-Malo, A.; Mejía-Garibay, B.; Ramírez-Corona, N.; Mani-López, E. Evaluation of Clean-Label Additives to Inhibit Molds and Extend the Shelf Life of Preservative-Free Bread. Microbiol. Res. 2025, 16, 179. https://doi.org/10.3390/microbiolres16080179
Hernández-Figueroa RH, López-Malo A, Mejía-Garibay B, Ramírez-Corona N, Mani-López E. Evaluation of Clean-Label Additives to Inhibit Molds and Extend the Shelf Life of Preservative-Free Bread. Microbiology Research. 2025; 16(8):179. https://doi.org/10.3390/microbiolres16080179
Chicago/Turabian StyleHernández-Figueroa, Ricardo H., Aurelio López-Malo, Beatriz Mejía-Garibay, Nelly Ramírez-Corona, and Emma Mani-López. 2025. "Evaluation of Clean-Label Additives to Inhibit Molds and Extend the Shelf Life of Preservative-Free Bread" Microbiology Research 16, no. 8: 179. https://doi.org/10.3390/microbiolres16080179
APA StyleHernández-Figueroa, R. H., López-Malo, A., Mejía-Garibay, B., Ramírez-Corona, N., & Mani-López, E. (2025). Evaluation of Clean-Label Additives to Inhibit Molds and Extend the Shelf Life of Preservative-Free Bread. Microbiology Research, 16(8), 179. https://doi.org/10.3390/microbiolres16080179

